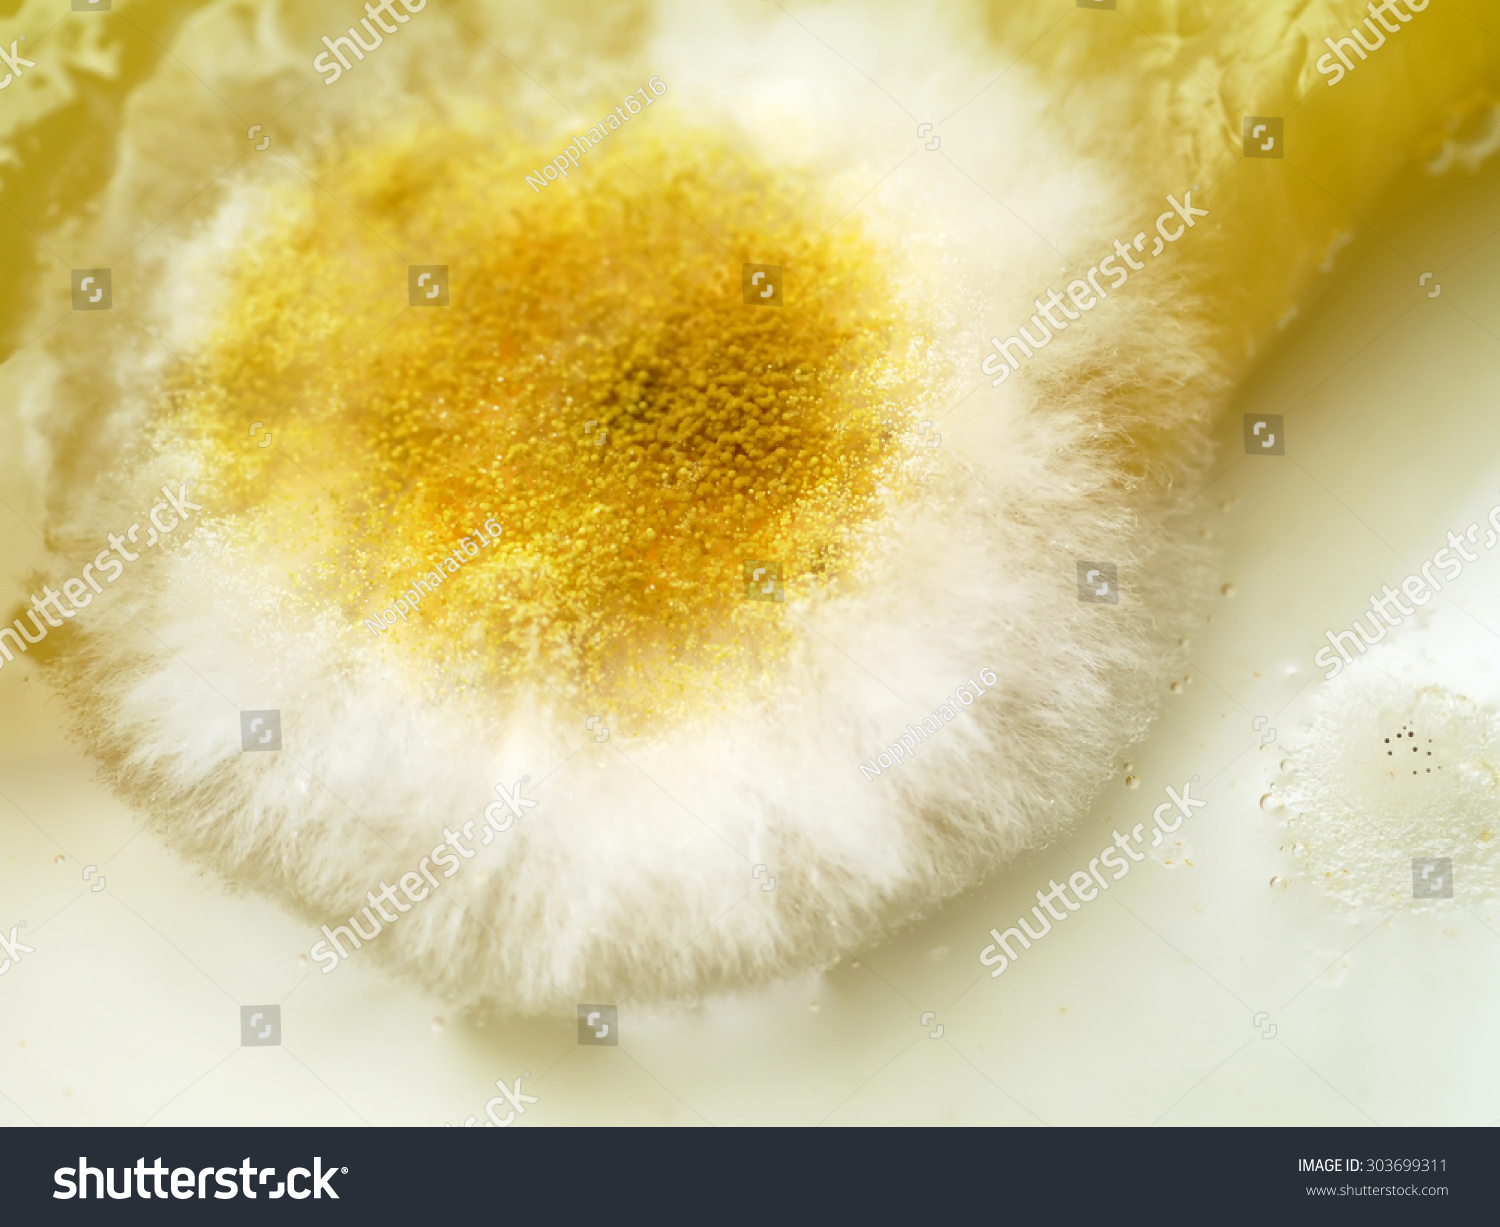
(匍枝根霉)-食品及饮料,自然-海洛创意(hellorf)-shutterstock中国

匍枝根霉

匍枝根霉fl-3及其在提取茯苓多糖中的应用的制作方法
图片尺寸1000x980
匍枝根霉病
图片尺寸268x201
(2)匍枝根霉 馒头上的匍枝根霉 匍 枝 根 霉 的 形 态
图片尺寸1080x810
(匍枝根霉)-食品及饮料,自然-海洛创意(hellorf)-shutterstock中国
图片尺寸1500x1227
葡枝根霉的无性生殖
图片尺寸344x480
灵芝栽培病虫防治-匍枝根霉,黑发菌
图片尺寸381x385
根霉属 - 生物学百科
图片尺寸890x847
如图分别为匍枝根霉和青霉的形态图,观察后完成下列问题.
图片尺寸429x258
请问图片1,2是匍枝根霉吗?图片3,4,5是放线菌还是霉菌?
图片尺寸800x761
专业生产匍枝根霉装片,生物教学(在线咨询),装片
图片尺寸699x700
没有作业的日子
图片尺寸689x510
刚栽葡萄,根上部这样,各位老师这是什么病害
图片尺寸720x960
苏科版七年级下册第5单元环境中生物的多样性第13章
图片尺寸720x540
识别青霉和匍枝根霉,并说出
图片尺寸525x311
室内盆景根部发霉了,什么原因?
图片尺寸1792x1344
匍枝根霉
图片尺寸620x410
绿化苗木常见的根部病害汇总
图片尺寸700x466
匍枝根霉,你的假根呢?
图片尺寸1080x1439
根霉
图片尺寸220x202
根霉菌
图片尺寸140x140